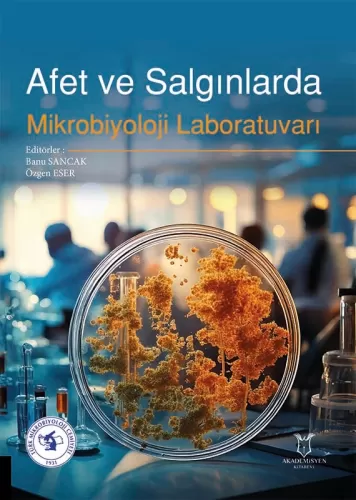
Afet ve Salgınlarda Mikrobiyoloji Laboratuvarı Banu SANCAK

Afet ve Salgınlarda Mikrobiyoloji Laboratuvarı
Liste Fiyatı :
2.250,00TL
İndirimli Fiyat :
1.800,00TL
Kazancınız :
450,00TL
Taksitli fiyat :
3 x 600,00TL
Havale/EFT ile :
1.764,00TL
9786253750503
136391
https://www.pelikankitabevi.com.tr/genel-konular/akademisyen-kitabevi/afet-ve-salginlarda-mikrobiyoloji-laboratuvari
Afet ve Salgınlarda Mikrobiyoloji Laboratuvarı
1800
KISIM 1 AFETLER
VE SALGINLAR Bölüm 1. Genel
Tanım, Afet Türleri ve Evreleri Bölüm 2. Afet ve Salgınların Sağlık Hizmeti Veren Kurumlara ve Tıbbi Mikrobiyoloji Laboratuvarlarına Etkileri KISIM 2 AFET
VE SALGINLARDA MİKROBİYOLOJİ LABORATUVARI A. Afet Öncesi Hazırlık (Preparedness) a) Laboratuvar
Biyogüvenliği (Biosafety) ve Biyoemniyet (Biosecurity) Bölüm 3. Risk Değerlendirme Bölüm 4. Laboratuvar Tasarımı ve Biyogüvenlik Bölüm 5. Laboratuvar İçi
Atık Yönetimi Bölüm 6. Laboratuvar İçi Dezenfeksiyon / Sterilizasyon Yönetimi Bölüm 7. Biyoemniyet b) Afet Eylem
Planı Bölüm 8. Afet Eylem Planı Oluşturulma Süreci
B. Afete Yanıtta Mikrobiyoloji Laboratuvarı
(Response) Bölüm 9. Örnek, Personel, Cihaz ve Kaynak Yönetimi Bölüm 10. Hızlı Tanı Testleri
Personel, Cihaz ve Kaynak Yönetimi Bölüm 10. Hızlı Tanı Testleri Bölüm 11. Erken
Uyarı Sistemi ve Sendromik Sürveyansla Mikrobiyoloji Laboratuvarının İlişkilendirilmesi (Bilgi Alma ve
Bildirim) C. Afette İyileşme Döneminde
Mikrobiyoloji Laboratuvarı (Recovery) Bölüm 12. İyileşme
Döneminde Mikrobiyoloji Laboratuvarının Yeri D. Mobil Laboratuvarlar ve Sahra
Laboratuvarları Bölüm 13. Mobil
ve Sahra Laboratuvarlarının Kurulması ve Sürdürülebilirliği E. Su Kaynaklarının Yönetimi Bölüm 14. Afetlerin
Su Kaynaklarına Etkileri ve Su Kaynaklı Salgınlar KISIM 3 AFET
SONRASI SALGINLAR VE MIKROBIYOLOJI LABORATUVARI A. Gastrointestinal Enfeksiyon Salgınları Bölüm 15. Bakteriyel Etkenler Bölüm 16. Viral Etkenler Bölüm 17. Paraziter
Etkenler B. Solunum Yolu Enfeksiyonu Salgınları Bölüm 18. Bakteriyel Etkenler Bölüm 19. Viral Etkenler C. Vektör - Ektoparazit Kaynaklı Salgınlar Bölüm 20. Bakteriyel Etkenler Bölüm 21. Viral Etkenler Bölüm 22. Paraziter
Etkenler KISIM 4 AFET SONRASI YARA ENFEKSIYONLARINA LABORATUVAR YAKLAŞIMI Bölüm 23. Clostridium tetani ve Clostridium perfringens
tetani ve Clostridium perfringens Bölüm 24. Hastane Enfeksiyonu Etkenleri Bölüm 25. Diğer Bakteriyel Etkenler Bölüm 26. Mantar Enfeksiyonları KISIM 5 BİYOTERÖRİZM Bölüm 27. Biyolojik
Savaş Ajanları ve Biyoterörizm
- Açıklama
KISIM 1 AFETLER
VE SALGINLAR Bölüm 1. Genel
Tanım, Afet Türleri ve Evreleri Bölüm 2. Afet ve Salgınların Sağlık Hizmeti Veren Kurumlara ve Tıbbi Mikrobiyoloji Laboratuvarlarına Etkileri KISIM 2 AFET
VE SALGINLARDA MİKROBİYOLOJİ LABORATUVARI A. Afet Öncesi Hazırlık (Preparedness) a) Laboratuvar
Biyogüvenliği (Biosafety) ve Biyoemniyet (Biosecurity) Bölüm 3. Risk Değerlendirme Bölüm 4. Laboratuvar Tasarımı ve Biyogüvenlik Bölüm 5. Laboratuvar İçi
Atık Yönetimi Bölüm 6. Laboratuvar İçi Dezenfeksiyon / Sterilizasyon Yönetimi Bölüm 7. Biyoemniyet b) Afet Eylem
Planı Bölüm 8. Afet Eylem Planı Oluşturulma Süreci
B. Afete Yanıtta Mikrobiyoloji Laboratuvarı
(Response) Bölüm 9. Örnek, Personel, Cihaz ve Kaynak Yönetimi Bölüm 10. Hızlı Tanı Testleri
Personel, Cihaz ve Kaynak Yönetimi Bölüm 10. Hızlı Tanı Testleri Bölüm 11. Erken
Uyarı Sistemi ve Sendromik Sürveyansla Mikrobiyoloji Laboratuvarının İlişkilendirilmesi (Bilgi Alma ve
Bildirim) C. Afette İyileşme Döneminde
Mikrobiyoloji Laboratuvarı (Recovery) Bölüm 12. İyileşme
Döneminde Mikrobiyoloji Laboratuvarının Yeri D. Mobil Laboratuvarlar ve Sahra
Laboratuvarları Bölüm 13. Mobil
ve Sahra Laboratuvarlarının Kurulması ve Sürdürülebilirliği E. Su Kaynaklarının Yönetimi Bölüm 14. Afetlerin
Su Kaynaklarına Etkileri ve Su Kaynaklı Salgınlar KISIM 3 AFET
SONRASI SALGINLAR VE MIKROBIYOLOJI LABORATUVARI A. Gastrointestinal Enfeksiyon Salgınları Bölüm 15. Bakteriyel Etkenler Bölüm 16. Viral Etkenler Bölüm 17. Paraziter
Etkenler B. Solunum Yolu Enfeksiyonu Salgınları Bölüm 18. Bakteriyel Etkenler Bölüm 19. Viral Etkenler C. Vektör - Ektoparazit Kaynaklı Salgınlar Bölüm 20. Bakteriyel Etkenler Bölüm 21. Viral Etkenler Bölüm 22. Paraziter
Etkenler KISIM 4 AFET SONRASI YARA ENFEKSIYONLARINA LABORATUVAR YAKLAŞIMI Bölüm 23. Clostridium tetani ve Clostridium perfringens
tetani ve Clostridium perfringens Bölüm 24. Hastane Enfeksiyonu Etkenleri Bölüm 25. Diğer Bakteriyel Etkenler Bölüm 26. Mantar Enfeksiyonları KISIM 5 BİYOTERÖRİZM Bölüm 27. Biyolojik
Savaş Ajanları ve BiyoterörizmStok Kodu:9786253750503Boyut:19x27Sayfa Sayısı:356Basım Yeri:AnkaraBasım Tarihi:2024
- Taksit Seçenekleri
- Axess KartlarTaksit SayısıTaksit tutarıGenel ToplamTek Çekim1.800,001.800,002900,001.800,003600,001.800,00Ziraat BankkartTaksit SayısıTaksit tutarıGenel ToplamTek Çekim1.800,001.800,002900,001.800,003600,001.800,00Maximum KartlarTaksit SayısıTaksit tutarıGenel ToplamTek Çekim1.800,001.800,002900,001.800,003600,001.800,00Diğer KartlarTaksit SayısıTaksit tutarıGenel ToplamTek Çekim1.800,001.800,002--3--
- Yorumlar
- Yorum yazBu kitabı henüz kimse eleştirmemiş.










